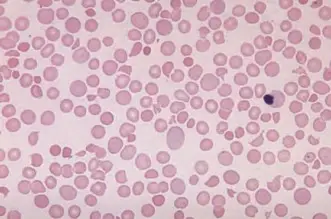
圖片

109年:(醫檢)血液(1)
某一女病人,發燒、腎功能異常及身體出現紫斑, PT 及 APTT 皆正常;血液抹片如下圖;檢體送特殊檢驗發現血中有 Ultra-large VWF ,下列何者為最可能的診斷?
AThrombotic thrombocytopenic purpura
BImmune thrombocytopenic purpura
CAcquired von Willebrand disease in acute phase
DThrombocytopenia due to severe sepsis
詳細解析
本題觀念:
本題考核血栓性血小板低下性紫斑症(thrombotic thrombocytopenic purpura, TTP)的診斷,重點在於整合臨床五聯徵、凝血結果、血液抹片所見及特殊檢驗(血中 Ultra-large VWF,即 ULvWF)進行鑑別診斷。TTP 的核心病理機制是 ADAMTS13(von Willebrand factor-cleaving protease)嚴重缺乏(活性 < 10%),導致超大型 von Willebrand factor(ultra-large VWF multimers)無法被裂解,蓄積於血中,引起廣泛性血小板微血栓形成。
影像分析:
血液抹片(低倍至中倍視野,Wright-Giemsa 染色)可見:
- 裂片紅血球(schistocytes / fragmented red blood cells):視野中可見大量形態不規則的紅血球碎片,包括盔狀(helmet cells)、三角形及彎刀形碎片,分布於各處正常紅血球之間。裂片紅血球是微血管病性溶血性貧血(microangiopathic hemolytic anemia, MAHA)的典型血液抹片特徵。
- 血小板減少:視野中幾乎看不到正常大小的血小板(血小板明顯稀少),與臨床血小板低下(thrombocytopenia)相符。
- **單顆
...(解析預覽)...

升級 VIP 解鎖圖文解析